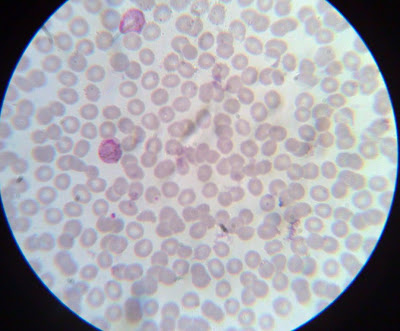

Anopheles
 Plasmodium vivax
Plasmodium vivax - Trofozoíto ameboide (Col. Giemsa)
 Plasmodium vivax
Plasmodium vivax - Trofozoíto anular (Col. Giemsa)
 Plasmodium vivax
Plasmodium vivax - Microgametocito (Macho) (Co. Giemsa)
 Plasmodium vivax
Plasmodium vivax - Macrogametocito (Hembra) (Col. Giemsa)
 Plasmodium vivax
Plasmodium vivax - Macrogametocito (Hembra) (Col. Giemsa)
 Plasmodium vivax
Plasmodium vivax - Esquizonte segmentado (Col. Giemsa)
 Plasmodium vivax
Plasmodium vivax - Esquizonte presegmentado (Col. Giemsa)

Estómago de Anophelinos mostrando ooquistes de
Plasmodium spp. Plasmodium falciparum
Plasmodium falciparum - Trombo parásito pigmentario (Col. Giemsa)
 Plasmodium falciparum
Plasmodium falciparum - Trombo parásito pigmentario (Col. Giemsa)
 Plasmodium falciparum
Plasmodium falciparum - Gametocito (Col. Giemsa)
 Plasmodium falciparum
Plasmodium falciparum - Trofozoíto anular (Col. Giemsa)
 Anopheles
Anopheles Plasmodium vivax - Trofozoíto ameboide (Col. Giemsa)
Plasmodium vivax - Trofozoíto ameboide (Col. Giemsa) Plasmodium vivax - Trofozoíto anular (Col. Giemsa)
Plasmodium vivax - Trofozoíto anular (Col. Giemsa) Plasmodium vivax - Microgametocito (Macho) (Co. Giemsa)
Plasmodium vivax - Microgametocito (Macho) (Co. Giemsa) Plasmodium vivax - Macrogametocito (Hembra) (Col. Giemsa)
Plasmodium vivax - Macrogametocito (Hembra) (Col. Giemsa) Plasmodium vivax - Macrogametocito (Hembra) (Col. Giemsa)
Plasmodium vivax - Macrogametocito (Hembra) (Col. Giemsa) Plasmodium vivax - Esquizonte segmentado (Col. Giemsa)
Plasmodium vivax - Esquizonte segmentado (Col. Giemsa) Plasmodium vivax - Esquizonte presegmentado (Col. Giemsa)
Plasmodium vivax - Esquizonte presegmentado (Col. Giemsa) Estómago de Anophelinos mostrando ooquistes de Plasmodium spp.
Estómago de Anophelinos mostrando ooquistes de Plasmodium spp. Plasmodium falciparum - Trombo parásito pigmentario (Col. Giemsa)
Plasmodium falciparum - Trombo parásito pigmentario (Col. Giemsa) Plasmodium falciparum - Trombo parásito pigmentario (Col. Giemsa)
Plasmodium falciparum - Trombo parásito pigmentario (Col. Giemsa) Plasmodium falciparum - Gametocito (Col. Giemsa)
Plasmodium falciparum - Gametocito (Col. Giemsa) Plasmodium falciparum - Trofozoíto anular (Col. Giemsa)
Plasmodium falciparum - Trofozoíto anular (Col. Giemsa)
No hay comentarios.:
Publicar un comentario